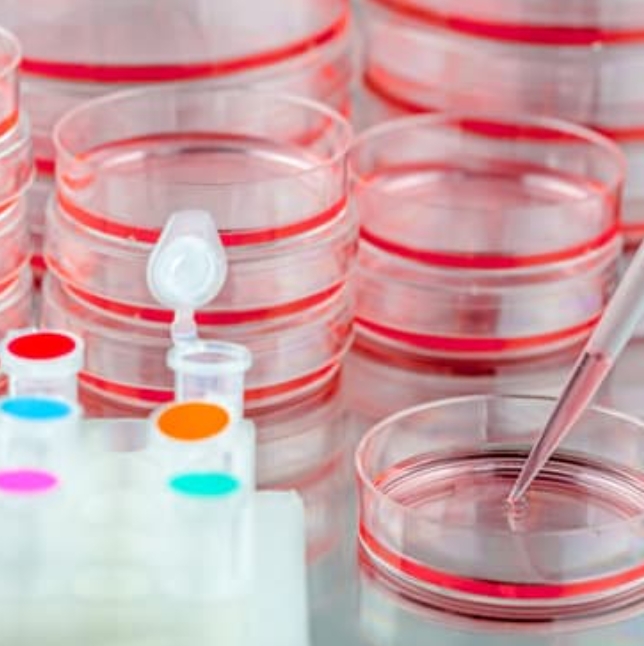
产品封面图

MycoSybr™ 支原体检测试剂盒(qPCR法)
- ¥3000¥2250特价
- xybiotech
- B01A01
- 上海
- 2026年04月02日
相关产品推荐更多 >
万千商家帮你免费找货
0 人在求购买到急需产品
- 详细信息
- 询价记录
- 文献和实验
- 技术资料
- 库存:
100
- 供应商:
上海杏园瑞民生物工程有限公司
- 英文名:
MycoSybrTM Mycoplasma qPCR Detection Kit
- 规格:
20次/50次/100次
| 规格: | 20次 | 产品价格: | ¥3000.0 |
|---|---|---|---|
| 规格: | 50次 | 产品价格: | ¥7250.0 |
| 规格: | 100次 | 产品价格: | ¥14000.0 |
便宜、快速、准确
支原体是生物制药生产、细胞治疗、高通量测序和组织工程中的常见细胞培养污染源。
支原体QPCR检测试剂盒使得支原体检测变得快捷、简便且可靠。可避免进行28天的培养基试验;短短数小时内即可获得结果。
| 特性 | |
| 样本制备 | 仅需2ul细胞培养基,无需进行核酸抽提。 |
| 设计严谨 | 使用试剂盒中的内质控品,对样本制备过程进行回收率计算。 |
| 特异性增强 | 可检测超过几乎所有常见的支原体,特异性探针确保不会检测到非特异性扩增子。 |
| 即刻检测,无需优化 | 提供的即用型试剂是您可即刻开始进行检测。 |
设计合理,检测快速准确
- 高检测灵敏度和特异性
- 优化的检测范围
- 可靠的再现性
- 简化的操作流程
欧洲细胞库(ECACC)规定,“支原体污染比细菌和真菌污染更为隐蔽。支原体污染很难检测,需要使用专门技术。这些支原体检测应当成为常规和定期质量控制筛查步骤中的一部分。”
美国国立卫生研究院(NIH)在一封关于细胞错误鉴定和交叉污染的公开信中,推荐实验室遵守细胞培养良好规范(GCCP)指南。这包括在实验室引入新细胞系时,需要建立对支原体进行检测的质量保证制度,接着才进行常规筛查,以确保它们无支原体污染。
相关产品:支原体清除试剂
风险提示:丁香通仅作为第三方平台,为商家信息发布提供平台空间。用户咨询产品时请注意保护个人信息及财产安全,合理判断,谨慎选购商品,商家和用户对交易行为负责。对于医疗器械类产品,请先查证核实企业经营资质和医疗器械产品注册证情况。
- 作者
- 内容
- 询问日期
文献和实验近年来,ZFN、TALEN、CRISPR/Cas9等基因组编辑技术可谓是层出不穷,尤其是CRISPR/Cas9,一出现便在全球范围内掀起一股热潮。同时,各大公司也开发出一系列相应的产品,其中一种至关重要的就是基因敲除阳性克隆筛选的试剂。 目前,市面上只有Genloci的Cruiser™、Transgenomic的SURVEYOR和NEB的T7EI这三种产品和测序这种方法,被用于基因敲除阳性克隆的筛选。然而,SURVEYOR是进口产品,价格贵,货期长;T7EI可以识别多种DNA结构,如十字
NEB 发布:GenomONE™ 为诱导 iPSC 形成「保驾护航」
。在本研究中分化诱导后,表达的转录因子被降解,从而改善后续程序分化的效率。由此可见,iPMSC 的重编程和衍生的重组转录因子提供了患者细胞再生医学的一种高效新方法。 高效新方法的发现,完全归功于灭活的病毒颗粒——仙台病毒包膜。请注意三点:灭活、病毒、包膜。具体来说,灭活使其无毒性,病毒衣壳蛋白的侵染能力,包膜的融合蛋白。也就是这三点作用机制,使得仙台病毒包膜可以高效地,精准地转染细胞,从而完成相关诱导。相关产品请点击:GenomONETM-Neo EX 仙台病毒包膜(1 只装)转染试剂
近日,赛业生物科技(Cyagen Biosciences)宣布推出其全球专利技术TetraOneTM KO,一种不仅在速度上媲美TALEN、CRISPR/Cas9(把ES打靶基因敲除/敲入鼠的定制周期降低至6个月),而且避免了TALEN、CRISPR/Cas9脱靶效应困扰的革命性技术。TetraOneTM KO的出现,是ES打靶技术制备基因敲除鼠的一个重大突破。基因组编辑的技术进展传统ES打靶、TALEN和CRISPR/Cas9是基因组编辑的三大技术及主要工具。新一代核酸酶基因编辑技术
技术资料暂无技术资料 索取技术资料










